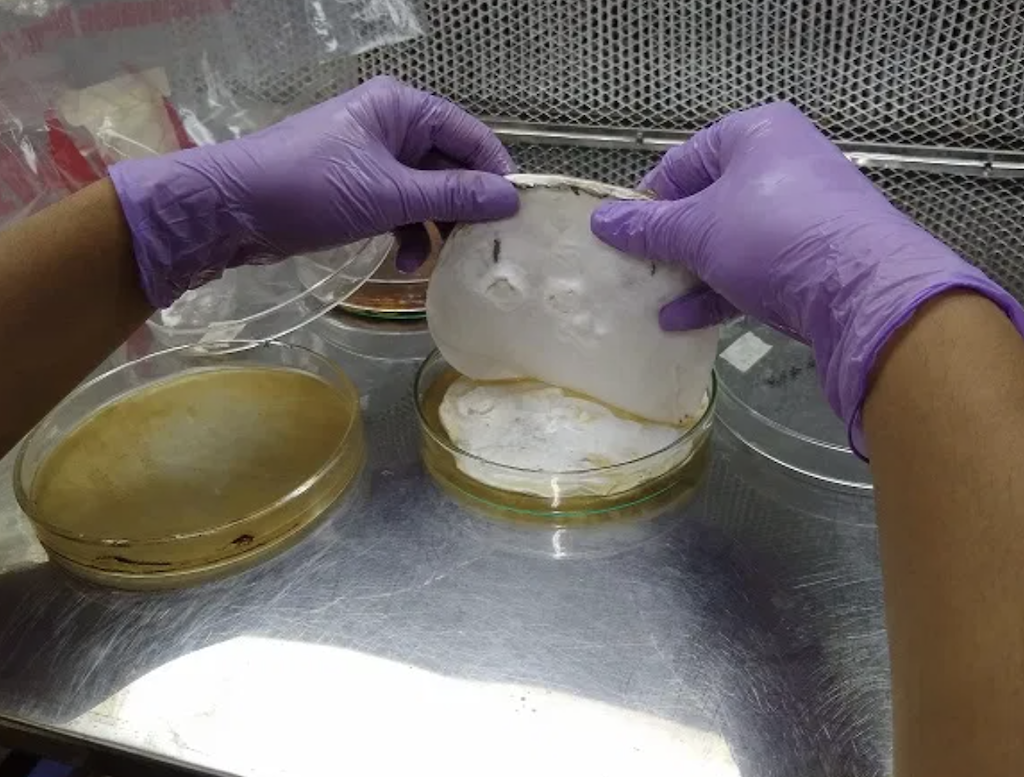

Phool is an Indian startup using floral waste to make vegan-friendly leather materials. While vegan leather alternatives on the market might be cruelty-free, they aren’t always eco-friendly if they are derived from plastic or synthetic substances. Crafted out of natural plant-based waste matter, the company’s ethical solution embraces circularity and sustainability.
Called “fleather”, the biomaterial startup’s leather alternative boasts the same durable qualities of its animal counterpart thanks to chitin, a polymer derived from leftover temple flowers. Not only does this mean recycling plant matter that would otherwise be thrown away, the end product, which functions and looks like real leather, is far less carbon-intensive and is also completely biodegradable.
“Leather contains collagen which provides it strength and durability, whereas fleather has chitin, a kind of protein, that gives it the same properties. Collagen and chitin are natural analogs, making fleather a perfect substitute for leather,” explains co-founder Ankit Agarwal, in an interview with Hindustan Times.
Intrigued by the formation of a leather-like white layer on unused piles of flowers, our R&D team discovered the growth of a microorganism which used flower petals as a nutritional source.
Ankit Agarwal, Co-Founder of Phool

Read: A complete guide to natural vegan leather alternatives, from coconut to cactus
Agarwal started Phool in 2017 (the name is a play on ful, the hindi word for flower) alongside Prateek Kumar. The Kanpur, Uttar Pradesh-based startup originally focused on converting discarded flowers into charcoal-free incense products, but later realised that they could also create other items like vegan-friendly animal-free leather.
“Intrigued by the formation of a leather-like white layer on unused piles of flowers, our R&D team discovered the growth of a microorganism which used flower petals as a nutritional source,” Agarwal said.
The company took to the lab to identify the biological species, grow similar strains and isolated the best performing ones. Then, Phool used their proprietary technique to extract the nutritional content from flowers, in the process incorporating additives, which helped to develop the final medium to enable the growth of the microorganism to create fleather.
“The tensile strength, elasticity and sheer resistance of fleather is matching or is rather superior to that of traditional leather.”
The startup is backed by the Indian Institute of Technology Kanpur (IIT). Professor Amitabha Bandyopadhyay of the biological sciences and bioengineering department in IIT Kanpur has described the company’s innovation as a “game changer” for the fashion industry.
The tensile strength, elasticity and sheer resistance of fleather is matching or is rather superior to that of traditional leather.
Ankit Agarwal, Co-Founder of Phool
It is also a particularly relevant solution to help transition India’s textile industry into more sustainable and cruelty-free alternatives. Currently, the country manufactures more than 3 billion square foot of hide each year – representing nearly 13% of the world’s hide production.
Vegan leathers, in particular, are on the uptrend as well. According to a recent report by analysts at Infinitum Global, demand for vegan leather will continue to rise by an annual rate of 49.9% to reach a whopping US$89.6 billion by 2025.
The research indicates that the primary reason for its rapid growth will be the evolving awareness about animal welfare and rights, which will send consumers looking for more animal-free products, especially in the footwear, garments and furniture industries. Infinitum Global also identified Asia as a predominant driving force of the global market, with consumers increasingly inclined to purchase animal-free products, from fashion to furniture.
Lead image courtesy of Phool / Shutterstock / designed by Green Queen Media.



